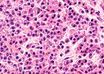

DCGI extends shelf life of Covishield from 6 to 9 months
PTI | Apr 01, 2021
Experimental hearing implant succeeds in registering brainwaves
IANS | Mar 31, 2021
Gum infection linked to elevated BP
IANS | Mar 31, 2021
Bone marrow transplant effective for multiple myeloma patients: Experts
IANS | Mar 31, 2021
Mutations could render COVID vaccine ineffective in a year: Experts
IANS | Mar 31, 2021
Bariatric surgery may reduce cancer risk for obese patients
IANS | Mar 31, 2021
Most read this week